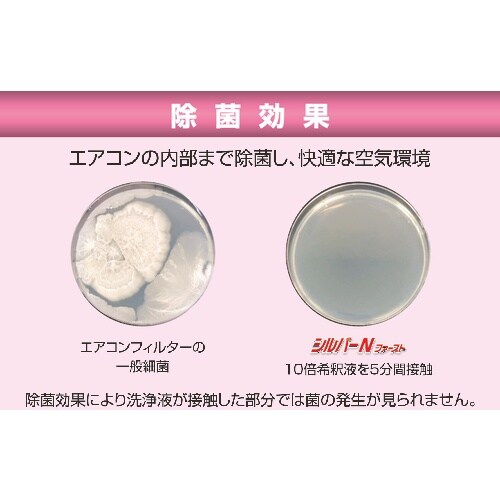
Linda シルバーNファースト5kg

その他掃除/清掃用品の売れ筋ランキング
- ¥3,019(税込) (税込)
- ¥337(税込) (税込)
- ¥826(税込) (税込)
- ¥638(税込) (税込) 〜
- ¥1,335(税込) (税込)
- ¥638(税込) (税込)
- ¥2,002(税込) (税込)
商品の特徴 |
強力な洗浄力と除菌効果でエアコンアルミフィンのメンテナンスに最適です。エアフィルタや熱交換器を洗浄することで、消費電力を20ー40%削減できCO2排出量を削減します。 |
|---|---|
商品仕様 |
|
メーカー情報 |
|
カタログ掲載ページ |
-/- |
| 注意事項 | ※【返品に関するご注意】この商品は直送品のため、お客様のご都合による返品はお受けできません。 |
|---|